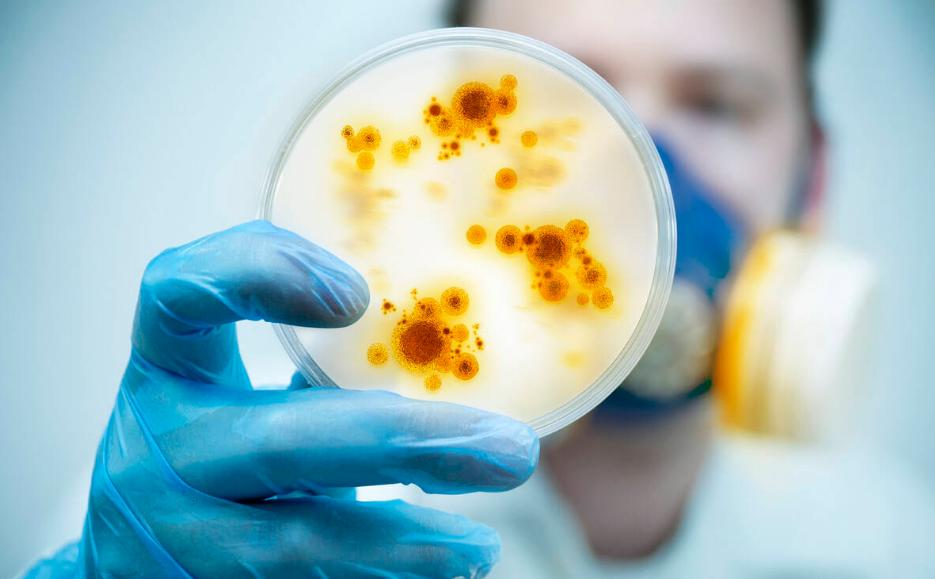
阿莫西林和消炎药有什么区别,阿莫西林是非类固醇消炎药吗

这几天,小刘感觉自己咽喉疼痛难忍,而且伴有流鼻涕的症状,想起几天前降温不注意,猜测应该是感冒了,就想在平时常备的药箱里找点药吃,而家里的药箱里只有维生素了,于是小刘前往附近的药店,对售药员说明了自己的情况,针对相关病症,店里的售药员给小刘推荐了几款治疗近期流感的特效药,并且叮嘱他如何按照正常的剂量服用。临走前,小刘想起家里药箱空了,便对售药员说:顺便给我拿点消炎药吧,阿莫西林就行。怎料,售药员和他说道:阿莫西林可不是消炎药,不能随便服用。
听闻小刘感到疑惑了,阿莫西林难道不是我们最常见的消炎药吗?莫非以前都“吃错药了”?

一、你真的了解什么是“阿莫西林”吗?
提起阿莫西林,相信大家都不陌生,药店里经常会看到,很多人的家庭药箱里都备有阿莫西林这种药品。由于它属于非处方药品,因此在普通药店我们都可以买到,但是你知道阿莫西林它到底是什么吗?
阿莫西林,又名安莫西林,它是一种最常用的半合成青霉素类广谱β-内酰胺类抗生素。通过它的定义我们可以知道,阿莫西林是一种青霉素,按照医学上的分类来说,它属于抗生素的一种,而并非是消炎药!它是应用非常广泛的口服半合成青霉素之一。通常我们所服用的阿莫西林药剂,是和克拉维酸合用制成的分散片,外形多成胶囊、片剂、分散片以及颗粒状等。
相信大家从小应该都服用过阿莫西林药品,那你知道它主要治疗什么病症吗?

根据研究发现,阿莫西林由于是一种青霉素,因此对于某些革兰氏阳性菌尤其有效,例如我们经常说的大肠杆菌、流血嗜血杆菌等。
日常生活中,阿莫西林适应症较多,首先就是非常熟悉的上呼吸道感染,通常表现为咽炎、扁桃体炎、中耳炎等症状。此类症状多由溶血性链球菌、葡萄球菌以及流血嗜血杆菌引起,因此阿莫西林的使用可以有效针对此类病症进行杀菌消毒,缓解病症。
此外,泌尿生殖道感染、下消化道感染、皮肤软组织感染等症状,皆可以使用阿莫西林对症治疗。不仅如此,阿莫西林还通常搭配其他药物联合使用,组合成非常著名的“四联疗法”来治疗幽门螺旋杆菌。但是值得注意的是,在进行阿莫西林药物使用之前,医生通常会为患者进行皮下试敏,来检测患者本身对于阿莫西林是否产生过敏反应等。

由于阿莫西林本身就是抗生素,因此根据个人身体素质情况,会有一定的不良反应,通常我们在服用阿莫西林药剂之前,医生也会叮嘱我们,一旦发现不良反应,应立即停药并前往医院寻求医生帮助。
服用阿莫西林后的不良反应症状需要我们注意,首先部分人会出现过敏反应,例如皮肤上出现急性*麻疹荨**、红斑等,更有甚者出现胸闷气短、呼吸困难等症状,患者在发现后切莫大意;其次,也会出现消化道过敏症状,例如恶心、呕吐、腹泻等;此外,少数人也会出现其他不良反应症状,例如头晕、焦虑、失眠、肢体运动不协调等等。建议在服用阿莫西林后出现上述症状,及时停药就医。
二、消炎药只有这两种,千万别认错了!
既然阿莫西林不是消炎药,而属于抗生素,那么什么是消炎药呢?我们又该怎样区分消炎药以及它的用途呢?

首先,消炎药其实就分为两种,分别为非甾体类抗炎药和甾体类抗炎药。
非甾体类抗炎药,它是一种不含有甾体结构的抗炎药。它的首要代表就是阿司匹林。自1898年阿司匹林首次合成后至今,已经有上百种药物逐渐被合成应用。它的主要功能是抗炎、抗风湿、止痛、退热以及抗凝血等。
常见药物除了阿司匹林外,像对乙酰氨基酚、布洛芬、尼美舒利等,都是我们经常在药店能看到的。因此,此类药物的适用病症也是比较常见的,例如各种类风湿性关节炎、骨关节炎、发热症状以及各种疼痛症状的缓解。
而甾体类抗炎药,又称之为糖皮质激素。其种类分为短效、中效和长效三种。它通常指类固醇类药物,也就是我们常说的激素。它的作用主要是阻止炎症细胞向发生炎症的部位移动集中,同时能够抑制炎症因子的释放,达到抗炎和免疫的效果。临床上常见的甾体类抗炎药有地塞米松、甲泼尼龙、强的松等等。它多用于较为严重的机体免疫功能障碍炎症,例如多发性肌炎、系统性红斑狼疮等。
通常情况下,对于上述两种药物的选择,只有较为严重的病症,我们会用到甾体类抗炎药。而日常较轻的镇痛解热类型药物选择,我们会选用非甾体类抗炎药。

三、消炎药和抗生素一样吗?到底该怎么用?
通过上文我们了解到,消炎药和抗生素其实是有本质区别的。虽然日常生活中我们吃的很多消炎药是属于抗生素,但是严格意义上来说,消炎药属于抗生素,但是抗生素并不属于消炎药,二者在很多方面是不一样的。
首先,在成分上是有区别的。抗生素通常是某些微生物或者其他生物在生命活动过程中所产生的化学物质,属于生物代谢后的产物。简单理解,抗生素的产生是由各种微生物相互作用产生的。
当然,也有部分半合成抗生素,但是总体而言,它是天然的或者人工半合成的,它的存在能够抑制或干扰其他生物或细胞的发育。像青霉素、头孢、氨基糖苷类等,都是常用的抗生素代表。而消炎药则不同,它包含我们上述的两种类型,通常是各种化学物质合成。

其次,二者在作用机制上也是有很大差别的。抗生素并不能直接对炎症进行反应,而是杀死或者干扰引起炎症的微生物,使之无法繁衍或者再生长,从而达到治疗的目的。其中的代表就是青霉素类或者头孢菌类抗生素。
而消炎药则对病毒或者微生物本身是不起作用的,它是通过对于机体炎症进行对抗和作用,来达到治疗的目的。
通过上文内容描述,相信大家对于消炎药和抗生素,应该有了初步了解,因此在日常生活中,在药物的选择上,切勿想当然,更不能根据以往的经验随意吃药,一旦适应症状不同,非常容易引起不良反应,对我们自身抵抗力和免疫力造成损伤。

四、消炎药经常吃,但是我们应该注意什么呢?
正所谓人吃五谷杂粮,岂有不生病的道理。生活中我们接触各类物品,每天有几万个细菌病毒围绕在我们身边,而吃的食物以及呼吸的空气中也存在各种不可避免的病菌,因此生病也实属正常。消炎药也就成为了生活中常见的药品,但是你知道服用消炎药应该注意什么吗?
首先,在服用消炎药之前,必须要遵循的原则是遵医嘱服用,这是最重要的。很多人喜欢凭借自己的经验之谈,到药店随便买一些消炎药或者抗生素服用,这一点是错误的。每种药品针对的病症以及服用剂量都不同,切勿盲目选择,对身体造成伤害。

其次,通常在初次使用一些药品之前,医生会对患者进行试敏,在此也提醒大家,对于自己会产生过敏反应的药品,一定要牢记,后续医生开药方或者进行点滴时,要记得提醒医生。
另外,在服用各类药物期间,我们的生活饮食习惯也要注意。戒烟戒酒是必要的,饮食要注意清淡,避免各类辛辣刺激性食物,太过于油腻辛辣的食物容易对我们身体本身造成一定刺激,在胃肠道内和各种药品发生反应,极容易破坏药性,且某些反应容易造成身体对身体的伤害,这也是我们经常忽略的一点。
不论怎样,我们在服用药品时一定要遵循医生的医嘱服用,为自己的健康负责!
参考文献:
合成非甾体消炎药前体有新法 山西化工 2022-02-15 期刊
公众对抗生素的3种错误认识及危害 临床合理用药杂志 2022-12-20 期刊
含阿莫西林胶囊的四联方案根除幽门螺杆菌的疗效及安全性分析 贵州医药 2022-09-28
消炎药和抗生素你知多少 家庭医学(下半月) 2020-10-15 期刊